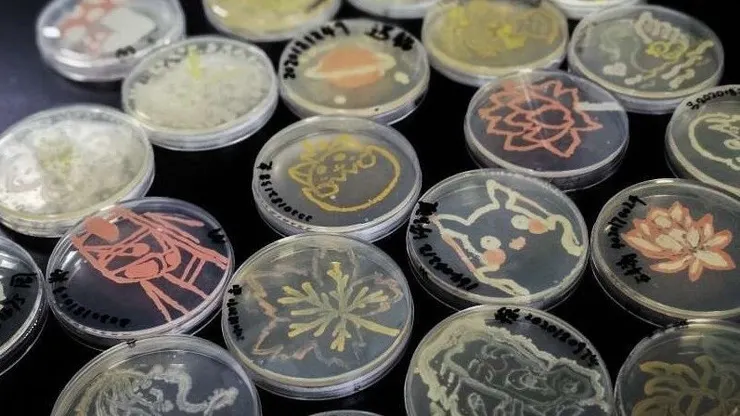
培養基中的菌落（圖片攝自網路）

晚上好呀,不知道閣下有沒有聽說過「 25 號宇宙」呢?
您對它有沒有什麼見解或感想呢?
今天,我想用一杯咖啡的時間,簡單聊聊 25 號宇宙以及我的一些感想。
(有點腦洞,請斟酌閱讀)
25 號宇宙是什麼?
1968 年,美國行為學家約翰·邦帕斯·卡爾宏在美國國家心理健康研究所協助下展開一場被後世廣為流傳的實驗—— 25 號宇宙,又稱「老鼠烏托邦」。
研究員準備了一個沙盒,確保食物及飲水充足,並隔絕包括天敵、疾病、惡劣氣候在內的一切威脅,理論上允許多達 3840 隻老鼠共同生活。他們預期在這樣的環境下,大部分老鼠都能夠頤養天年(原文是寫 "I suspect that it is well past menopause.",直譯就是「我猜牠們應能輕鬆活過更年期」)。實驗開始時,這個烏托邦「遷入」了 8 位居民,沙盒壁面光滑,意味著牠們(及後代)將一直生活在這個地方。
實驗結果
隨著實驗進行,鼠群規模發展大致可分為以下四個階段:
Phase A(適應期):最開始的 104 天,這 8 隻老鼠忙於社交和探索新環境無暇交配,族群數量穩定在 8 隻(廢話)。
Phase B(對數期):隨著第 1 隻「本地鼠」出生後,鼠群規模爆炸式增長,平均約每 55 天翻倍一次。
Phase C(穩定期):鼠群規模在第 315 天來到了 620 隻後,增長速率顯著下降,並於第 560 天見頂(2200 隻)。
Phase D(衰亡期):見頂後不久便不再有新老鼠出生,整個族群緩慢迎向終結。

卡爾宏將老鼠族群發展分為 4 個階段,依序為 Phase A ~ D。此圖為對數圖,任一點斜率恰為鼠群規模擴張速度(圖片攝自其著作 Death Squared The Explosive Growth and Demise of a Mouse Population)
發生了什麼?
正常雄鼠會相互爭奪領地,由此牠們在 Phase B 開始逐步建立起牠們的社會與階級:較為強壯的個體佔據著沙盒邊緣的「高級住宅區」並積極繁衍後代;而在競爭中落敗的老鼠們,則聚集在沙盒中央附近遊蕩。值得注意的是:前者通常是對後者不屑一顧的(除非他們來搶領地);而後者之間卻時常發生無端的攻擊行為(俗稱菜雞互啄)。
到了 Phase C 後,情況進一步惡化:越來越多老鼠選擇「躺平」,加入遊蕩者的行列;而高級住宅區的老鼠們也不好過,鼠口增長帶來了愈發嚴重的競爭,牠們為防禦領地疲於奔命,久而久之,研究員發現牠們的防禦範圍和頻率都越來越小,不少甚至選擇放棄領地...
至於放棄領地的雄鼠去哪了?...當然是沙盒中央啊 ~😉。
與此同時,雌鼠失去雄鼠的保護,對周遭產生極大的攻擊性一一甚至包括自己的幼崽。
另外,研究員發現了一種特別的雄鼠:牠們不社交、不繁衍、也不爭奪領地,而是將其除了吃跟睡以外的時間都用於梳理毛髮。他們將這些老鼠稱為“beautiful ones”。
整個老鼠社會,就是在這種氛圍之下逐步走向崩潰的。
呃...寫到這邊,我相信閣下一定認為我要拿這項實驗結果類比人類社會了...(畢竟,就連卡爾宏本人也是這麼寫的)
但是呢,我想從另一個角度切入這件事...
殊途同歸
經常養細菌的人都知道:一群培養基中的細菌,其族群數量會在短暫延遲後開始指數性增長,隨著培養基中的養分耗盡而趨於穩定,再來就是衰退...
等等,這不就跟 25 號宇宙的實驗結果一模一樣嗎?

一個典型的細菌生長曲線。為了方便和上圖進行比對,此圖也故意畫成對數圖(圖片來源:手繪)
老鼠,一個腦部發達的高等哺乳類動物,居然表現出和細菌幾乎一樣的生長曲線?
看來老鼠和細菌的差別好像也沒有想像中大啊...
那麼,問題來了:人類憑什麼認為自己不一樣?
社會?老鼠、甚至是細菌,也存在著與其它同類交流乃至共生的法子。
文明?沒有哪兩個菌落是完全相同的,也就是說,每個菌落都有獨屬於它的「特性」。
這是否意味著:文明其實並不是人類的專利?又或者說,每個菌落都是一個特別的文明?(雖然這看起來像在較真,然而我實在很好奇:若存在更高維的觀察者,祂們看我們的感覺,會不會就像是我們看培養基中的細菌那樣?🤔)
培養基中的菌落(圖片攝自網路)
當然,我無意詆毀人類至今為止取得的成就,也非宣揚一種悲觀的宿命論。
只要實驗員在培養基中添加一點「養分」(對 25 號宇宙而言則是「空間」),我們興許能夠將文明重置為第二階段。
實驗僅僅只是預演了一個封閉系統的終結。
結語
2026 年,自由主義、個人主義大行其道。
當社會逐漸將傳統視為累贅,一切背離傳統的行徑紛紛被包裝成進步的象徵,我便不免回想起 25 號宇宙中,一個(曾被視為)烏托邦的殞落。
如果說,文明真有先進與落後之別;
那麼路途的終點,或許細菌和老鼠已經悄悄給過我們答案。
最後,我想以卡爾宏的話為全文做個總結:
「...對於像人類如此複雜的動物來說,我們沒有合乎邏輯的理由去認為,類似的一連串事件不會同樣導致物種的滅絕。如果角色實踐的機會遠遠供不應求,無法滿足那些有能力且期盼填補這些角色的人,那麼隨之而來的將只有暴力以及社會組織的瓦解 。在這種環境下出生的個體將會與現實嚴重脫離,以至於他們甚至連產生『疏離感』的能力都沒有 。他們最複雜的行為將變得支離破碎;而在後工業化的文化—概念—科技社會中,為了生活而獲取、創造與運用思想的過程也將受到阻礙。正如老鼠的生物性繁衍包含了該物種最複雜的行為,人類的思想性繁衍(創造)亦是如此。喪失了這些各自專屬的複雜行為,即意味著物種的滅絕 。」
晚安,祝您有個愉快的一天。















